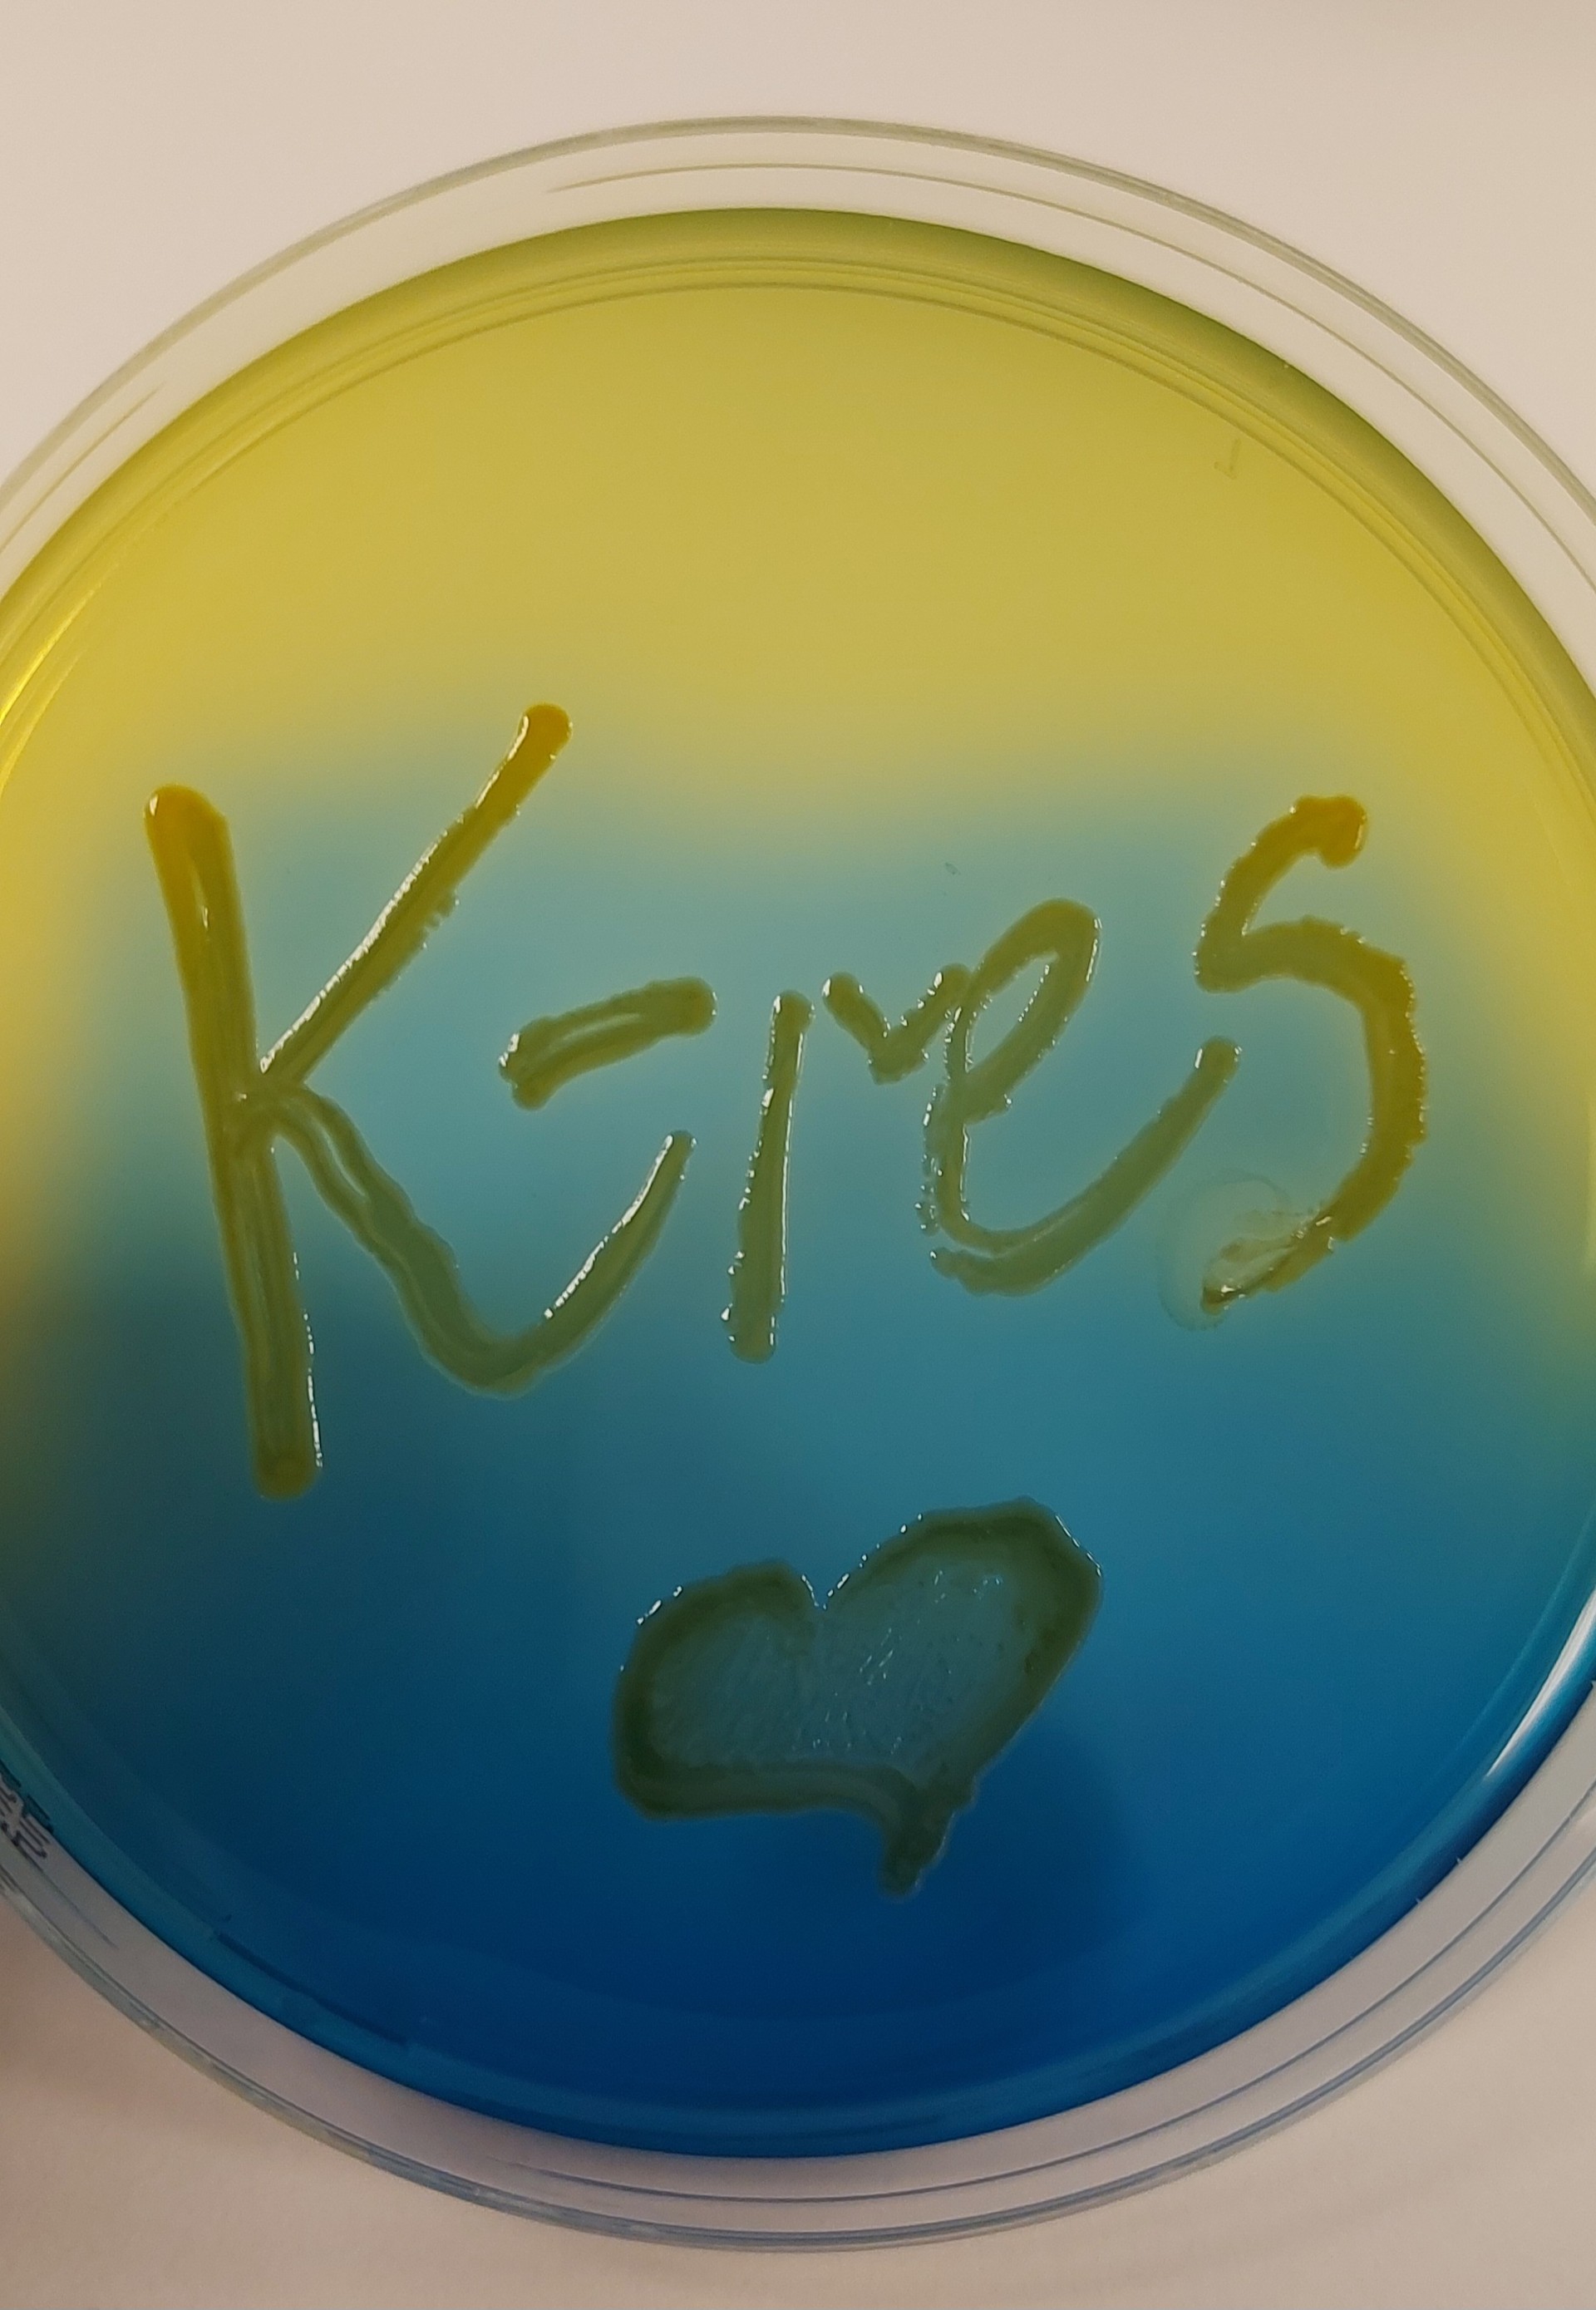
Sirkel hvor det står K-res

Nasjonalt senter for påvisning av antibiotikaresistens
K-res
K-res skal bygge opp og spre kompetanse om påvisning av antibiotikaresistente bakterier og ivareta utvalgte nasjonale referansefunksjoner.
Nyheter fra K-resVårt mål er å spre kunnskap til alle helseregioner for å sikre god og likeverdig kvalitet. Informasjon til allmennheten er også viktig.
Hovedaktiviteten vår er rettet mot leger og bioingeniører i de medisinske mikrobiologiske avdelingene i spesialisthelsetjenesten samt infeksjonsmedisinere og smittevernpersonell.
Senteret har som mål å bygge opp kompetanse i alle helseregioner for å sikre bedre kvalitet og at det etableres faglige nettverk som kan videreføre dette arbeidet lokalt. Mandat for K-res er forankret i interregionalt fagdirektørmøte.
K-res har utarbeidet en rekvisisjon som skal følge stammer som sendes til oss for nærmere undersøkelser. Vi oppfordrer alle rekvirenter til å benytte denne rekvisisjonen, slik at vi mottar den nødvendige informasjonen for å kunne tolke analyseresultatene på en best mulig måte.
Rekvisisjon K-res (word)
Rekvisisjon K-res (pdf)
Prioriterte analyser ved K-res 2026
Referanseundersøkelser:
- Karbapenemaseproduserende Gram-negative staver
K-res utfører følsomhetstesting på et utvidet panel av antibiotika, fenotypiske og biokjemiske tester samt PCR på innsendte isolater med mistanke om karbapenemaseproduksjon. Alle positive funn helgenomsekvenseres. - Overførbar colistinresistens hos Gram-negative staver
K-res utfører rutinemessig følsomhetstesting for kolistin med referansemetoden (mikrobuljongfortynning) på innsendte isolater med mistanke om karbapenemaseproduksjon og etter spesifikt ønske fra rekvirent. Kolistinresistente isolater gjennomgår PCR-/helgenomanalyse i forhold til overførbare kolistinresistensgener (mcr-gener). Andre isolater som gjennomgår helgenomsekvensering uavhengig av kolistinresistens vil også undersøkes for overførbare kolistinresistensgener. - Vancomycinresistente enterokokker
Nytt av året er at K-res ønsker tilsendt alle (kliniske og bærerskap) VRE isolater og/eller helgenomsekvenserings data på disse. K-res bekrefter resistensfenotypen ved funn av diskrepans mellom feno- og genotype med referansemetoden (mikrobuljongfortynning), og utfører genetisk karakterisering med PCR og helgenomsekvensering. - Linezolidresistente enterokokker
K-res bekrefter resistensfenotypen med referansemetoden (mikrobuljongfortynning) og utfører genetisk karakterisering med PCR og helgenomsekvensering.
Kontaktinformasjon
For spørsmål kontakt Kristin Hegstad (kristin.hegstad@uit.no), Ørjan Samuelsen (orjan.samuelsen@unn.no) eller Arnfinn Sundsfjord (arnfinn.sundsfjord@uit.no).
Vedlegg:
Prioriterte analyser K-res -pdf
For å overvåke og oppdage utbrudd av referansemikrober utfører K-res helgenomsekvensering eller mottar genomsekvenser på referansemikrobene. Genomsekvensene blir videre analysert med bioinformatiske verktøy for å undersøke mulig slektskap mellom isolater. Hvis det påvises slektskap mellom isolater vil K-res sende en slektskapsrapport til rekvirerende laboratorium for oppfølgning. Følgende dokument beskriver håndtering av påvist genetisk slektskap:
Håndtering av genetisk slektskap
Slektskapsrapporter sendes kun ut hvis det påvises genetisk slektskap. Overordnet genetisk analyse presenteres i egen årlig rapport og i NORM rapporten.
Det er oppnevnt en referansegruppe med representanter fra hver helseregion hvis målsetning er å sikre en nasjonal forankring og lik tilgang til de høyspesialiserte tjenestene. K-res har møte med referansegruppen årlig og presenterer her sine aktiviteter og planer.
Mandat for referansegrupper for nasjonale sentre
Følgende representanter sitter i referansegruppen:
Helse Sør-Øst:
Overlege Dagfinn Skaare (leder)
Mikrobiologisk avdeling,
Sykehuset i Vestfold,
Postboks 2168 Postterminalen,
3103 Tønsberg.
Helse Vest:
Overlege Iren Löhr,
Avdeling for medisinsk mikrobiologi
Stavanger universitetssjukehus
Postboks 8100
4068 Stavanger
Helse Midt-Norge:
Overlege Kyriakos Zaragkoulias
Avdeling for medisinsk mikrobiologi
St. Olavs hospital
7006 Trondheim
Helse Nord:
Overlege Kristoffer Endresen
Mikrobiologisk fagområde, Avd. for laboratoriemedisin
Nordlandssykehuset
8092 Bodø
Bruker-representant:
Bioingeniør Siri Haug Hänsgen
Avdeling for mikrobiologi og smittevern
Akershus universitetssykehus
Postboks 1000
1478 Lørenskog
Folkehelseinstituttet:
Overlege Miriam Sare
Seksjon for resistens og infeksjonsforebygging
Folkehelseinstituttet
Postboks 222 Skøyen
0213 Oslo
Smittevern-representant:
Smittevernoverlege Marjut Anneli Sarjomaa
Smittevern Sykehuset Telemark
Postboks 2900 Kjørbekk
3710 Skien
NORM:
Overlege Gunnar Skov Simonsen
Avdeling for mikrobiologi og smittevern,
Universitetssykehuset Nord-Norge,
9038 Tromsø
Representant fra K-res:
Professor Ørjan Samuelsen
K-res
Avdeling for mikrobiologi og smittevern
Universitetssykehuset Nord-Norge
9038 Tromsø
NSAS-Nasjonalt senter for antibiotikabruk i sykehus ved Haukeland sykehus skal være en drivende kraft for riktig bruk av antibiotika i norske sykehus, og slik bidra til å bremse spredning av resistente bakterier. K-res deltar sammen med NSAS i arbeidet med nasjonale faglige retningslinjer for bruk av antibiotika i spesialisthelsetjenesten.
Faglige rapporter
Fagfellevurderte vitenskapelige publikasjoner
Vitenskapelige publikasjoner.pdf
Laboratoriet
Telefon 776 27032
E-post:
K-res@unn.no
Ved faglige spørsmål:
- Kristin Hegstad, forsker: e-post: kristin.hegstad@uit.no og telefon (+47) 776 46351
-
Ørjan Samuelsen, forsker: e-post orjan.samuelsen@unn.no og telefon (+47) 776 27043 eller 97 65 37 16
- Arnfinn Sundsfjord, medisinskfaglig ansvarlig: e-post arnfinn.sundsfjord@uit.no og telefon (+47) 90 61 61 18